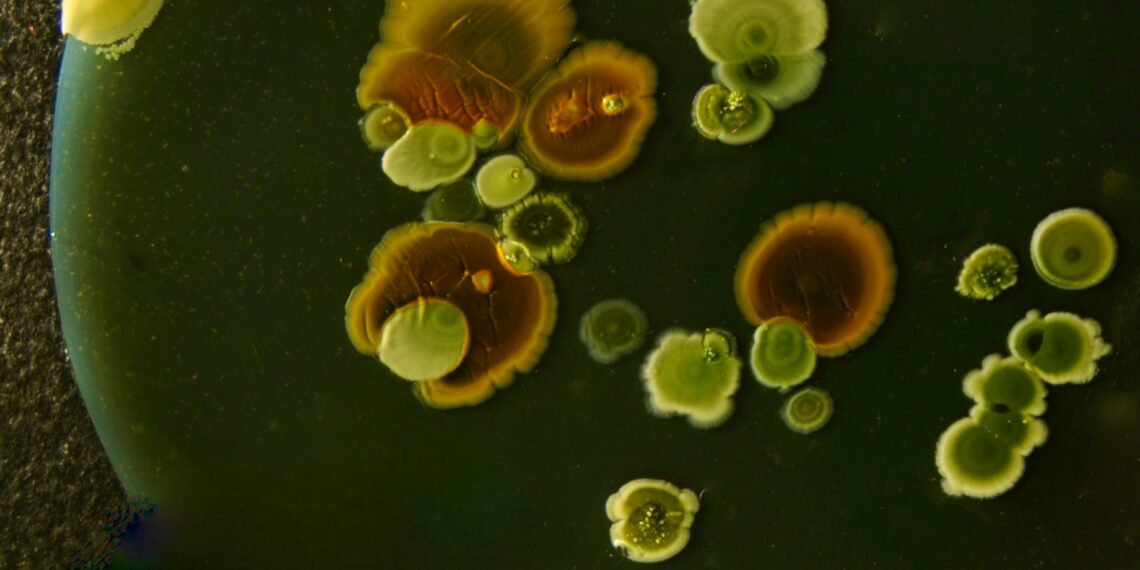
Gyvi mikrorobotai? Mokslininkai iš bakterijų kuria tai, kas skamba kaip iš fantastikos

Pagalvojus apie kompasą, dažniausiai prieš akis iškyla rodyklė, žemėlapis ir žmogus, bandantis nepasiklysti miške. Tačiau kai kurios bakterijos nešiojasi kompasą savo viduje – ir tai nėra metafora. Jų ląstelėse veikia miniatiūrinė sistema iš magnetinių nanodalelių, kuri visą ląstelę išrikiuoja taip pat, kaip kompaso rodyklę Žemės magnetiniame lauke.
Naujausi matavimai, atlikti su paviene bakterija, parodė, kad šis natūralus mechanizmas yra ne tik įspūdingas, bet ir fiziškai pakankamai stiprus, kad patikimai veiktų realiame pasaulyje.
Bakterija, kuri neplaukioja aklai
Drėgnuose nuosėdų sluoksniuose, dugno zonose ir vandenyse, kur sąlygos gali smarkiai keistis vos per kelis centimetrus, kryptis tampa gyvybiškai svarbi. Mikroorganizmams tai nėra filosofinis klausimas – tai energijos sąnaudos. Jeigu plaukioji chaotiškai, švaistai laiką, o laikas mikromastelyje yra toks pat negailestingas išteklius kaip deguonis.
Čia pasirodo magnetotaksija. Bakterija iš esmės ne „nusprendžia“, o paklūsta fizikai. Jos viduje išsidėstęs magnetosomų – smulkių magnetinių dalelių, uždarų membraninėse struktūrose – grandinėlė. Visa ši grandinė elgiasi kaip mažytė kompaso rodyklė, kuri išrikiuoja ląstelę lygiagrečiai magnetinio lauko linijoms. Taip judėjimas įgyja aiškią prasmę: vietoj atsitiktinio blaškymosi erdvėje bakterija ima judėti tarsi magnetine autostrada.
Kompasas iš nanodalelių ir ilgai neatsakytas klausimas
Mokslininkai jau seniai žinojo, kad magnetosomai egzistuoja ir kad bakterijos geba orientuotis pagal Žemės magnetinį lauką. Tačiau liko praktiškas klausimas: kokio tiksliai dydžio yra magnetinė grandinėlės jėga pavienėje ląstelėje ir kiek stabiliai ji išlaiko savo orientaciją?
Didžioji dalis ankstesnių matavimų buvo atliekami su ištisomis bakterijų populiacijomis. Tai visuomet iškraipo vaizdą: vienos ląstelės turi ilgesnes magnetosomų grandinėles, kitos – trumpesnes, vienos yra geresnės būklės, kitos jau silpstančios. Tokie vidurkiai daug pasako apie populiaciją, bet ne apie konkretų, valdomą objektą.
Lūžis įvyko tada, kai pavyko išmatuoti magnetines savybes vienos vienintelės bakterijos, nebespėliojant iš „minios“. Tai itin svarbu galimiems technologiniams pritaikymams: ten dirbama ne su statistika, o su atskiromis struktūromis, kurios privalo elgtis nuspėjamai.
Eksperimente pavienė bakterija buvo pritvirtinta prie itin plonos mikrosijos – tarsi smulkutės spyruokliuojančios sijos. Tuomet stebėta, kaip skirtinguose magnetiniuose laukuose kinta šios sijos virpesiai. Šiuose mikroskopiniuose dažnio pokyčiuose užkoduota informacija apie bakterijos magnetinį momentą ir tai, kiek tvirtai ji išlaiko savo orientaciją.
Rezultatai buvo papildyti elektroninės mikroskopijos vaizdais ir kompiuteriniais modeliavimais, kad fizikiniai matavimai būtų tiksliai susieti su tuo, kas iš tikrųjų vyksta ląstelės viduje. Taip pavyko patikimai įvertinti, jog magnetosomų grandinėlė yra pakankamai stipri, kad natūraliomis sąlygomis išrikiuotų bakteriją lygiagrečiai Žemės magnetiniam laukui – būtent taip, kaip ir leido spėti biologinė intuicija.
Kur baigiasi gamtos išmonė ir prasideda ribojimai?
Ši sistema yra stabili, tačiau ne nepažeidžiama. Labai stiprūs išoriniai magnetiniai laukai gali sutrikdyti bakterijos orientaciją. Tai svarbu žmonėms, galvojantiems apie tokių bakterijų panaudojimą kaip mikrorobotų, valdomų magnetiniu lauku. Tokie eksperimentai iš esmės nubrėžia ribas: parodo, kur magnetinis laukas dar yra tikslus įrankis, o kur tampa „kūju“, išderinančiu kompasą.
Stebėta ir tai, kad keičiant lauko kryptį dalis magnetinių dalelių ląstelėje staiga „peršoka“ į kitą orientaciją – atskirai arba mažomis grupėmis. Toks elgesys gerai atitinka daugelio tarpusavyje sąveikaujančių nanomagnetų sistemos vaizdą. Gamtoje tai nekelia problemų: Žemės magnetinis laukas yra per silpnas, kad sukeltų tokius staigius persijungimus analogiškomis sąlygomis, o be to, bakterija nėra priversta būti standžiai pritvirtinta, kaip laboratorijoje.
Tačiau technologiniu požiūriu tai aiški užuomina: norint patikimai valdyti tokias bakterijas, reikės ne vien stipraus, bet ir labai subtiliai dozuojamo magnetinio lauko.
Nuo mikromedicinos iki „juodo darbo“ vandenyje
Girdint apie magnetu valdomas bakterijas, vaizduotė pirmiausia krypsta į mediciną. Tai pagrįsta: idėja naudoti magnetotaktines bakterijas kaip nešiklius, kuriuos galima nukreipti magnetiniu lauku, moksliniuose darbuose pasirodo nuolat. Tačiau medicinai būtinas maksimalus prognozuojamumas – objektas, kuris turi pasiekti tiksliai apibrėžtą vietą organizme, negali būti valdomas „maždaug“.
Toks pavienės ląstelės matavimas čia tampa tarsi pagaliau sufokusuota nuotrauka: jis dar neišsprendžia visų problemų, bet leidžia kurti sistemas remiantis tiksliomis, o ne apytikrėmis vertėmis.
Antroji tyrimų kryptis – gerokai žemiškesnė, bet galbūt greičiau pritaikoma praktikoje: vandens valymas. Jeigu bakterijos geba surišti tam tikrus teršalus, o vėliau jas galima surinkti magnetu, tai tampa patrauklia, elegantiška inžinerine išeitimi. Tačiau ir čia iškyla tas pats iššūkis – mastelis ir kontrolė.
Norint, kad tokia sistema veiktų ne laboratorinėje kolboje, o realioje valymo įrangoje, būtina tiksliai žinoti, kaip pavienė bakterija elgiasi konkrečiame lauke, sraute ir aplinkoje. Būtent šioje vietoje naujieji tyrimai ir užpildo iki šiol trūkstamą dėlionės dalį.